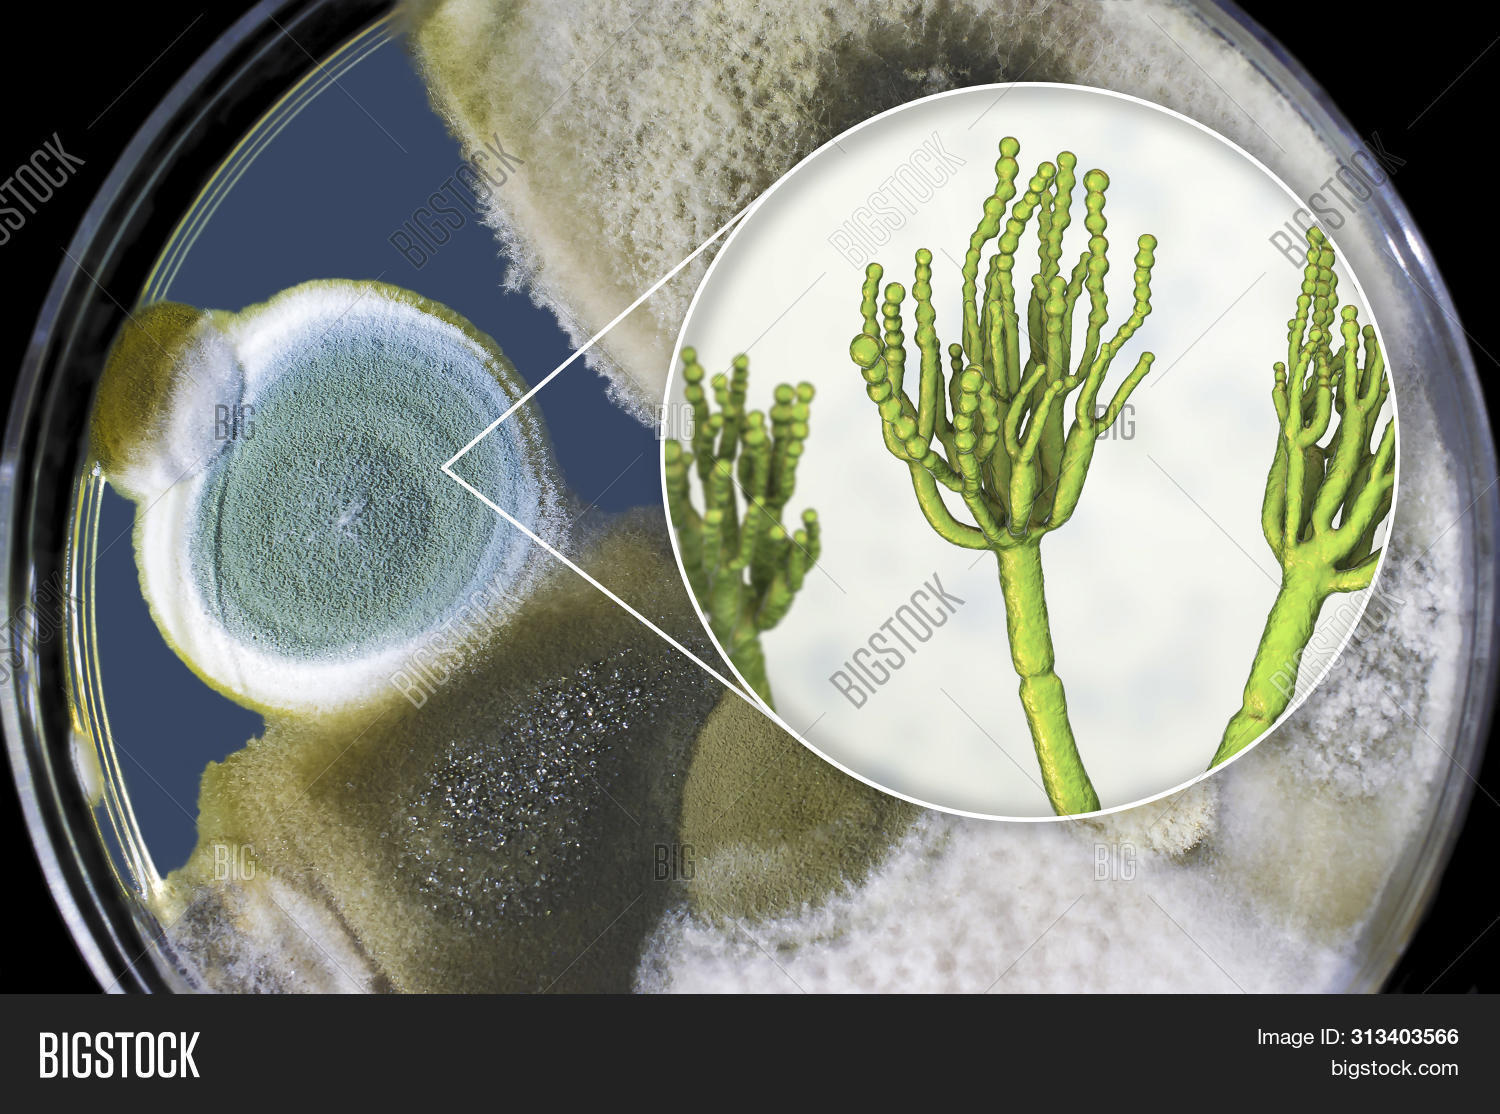

Выращивание пеницилла
10 спиши вставь пропущенные буквы черепаха
Погода в гусеве почасовая калининградская
Рисуем по координатам 6 класс математика животных
Лодка за 10 минут
G major collection
Почему на тибетском нагорье
Ln pro карандаш
Сколько можно пить йодомарин
Меню гамбургер тильда
Магазин победа набережные челны каталог
Every world перевод
To protect our users
Плата управления пароконвектомата
Выращивание пеницилла 102 фото